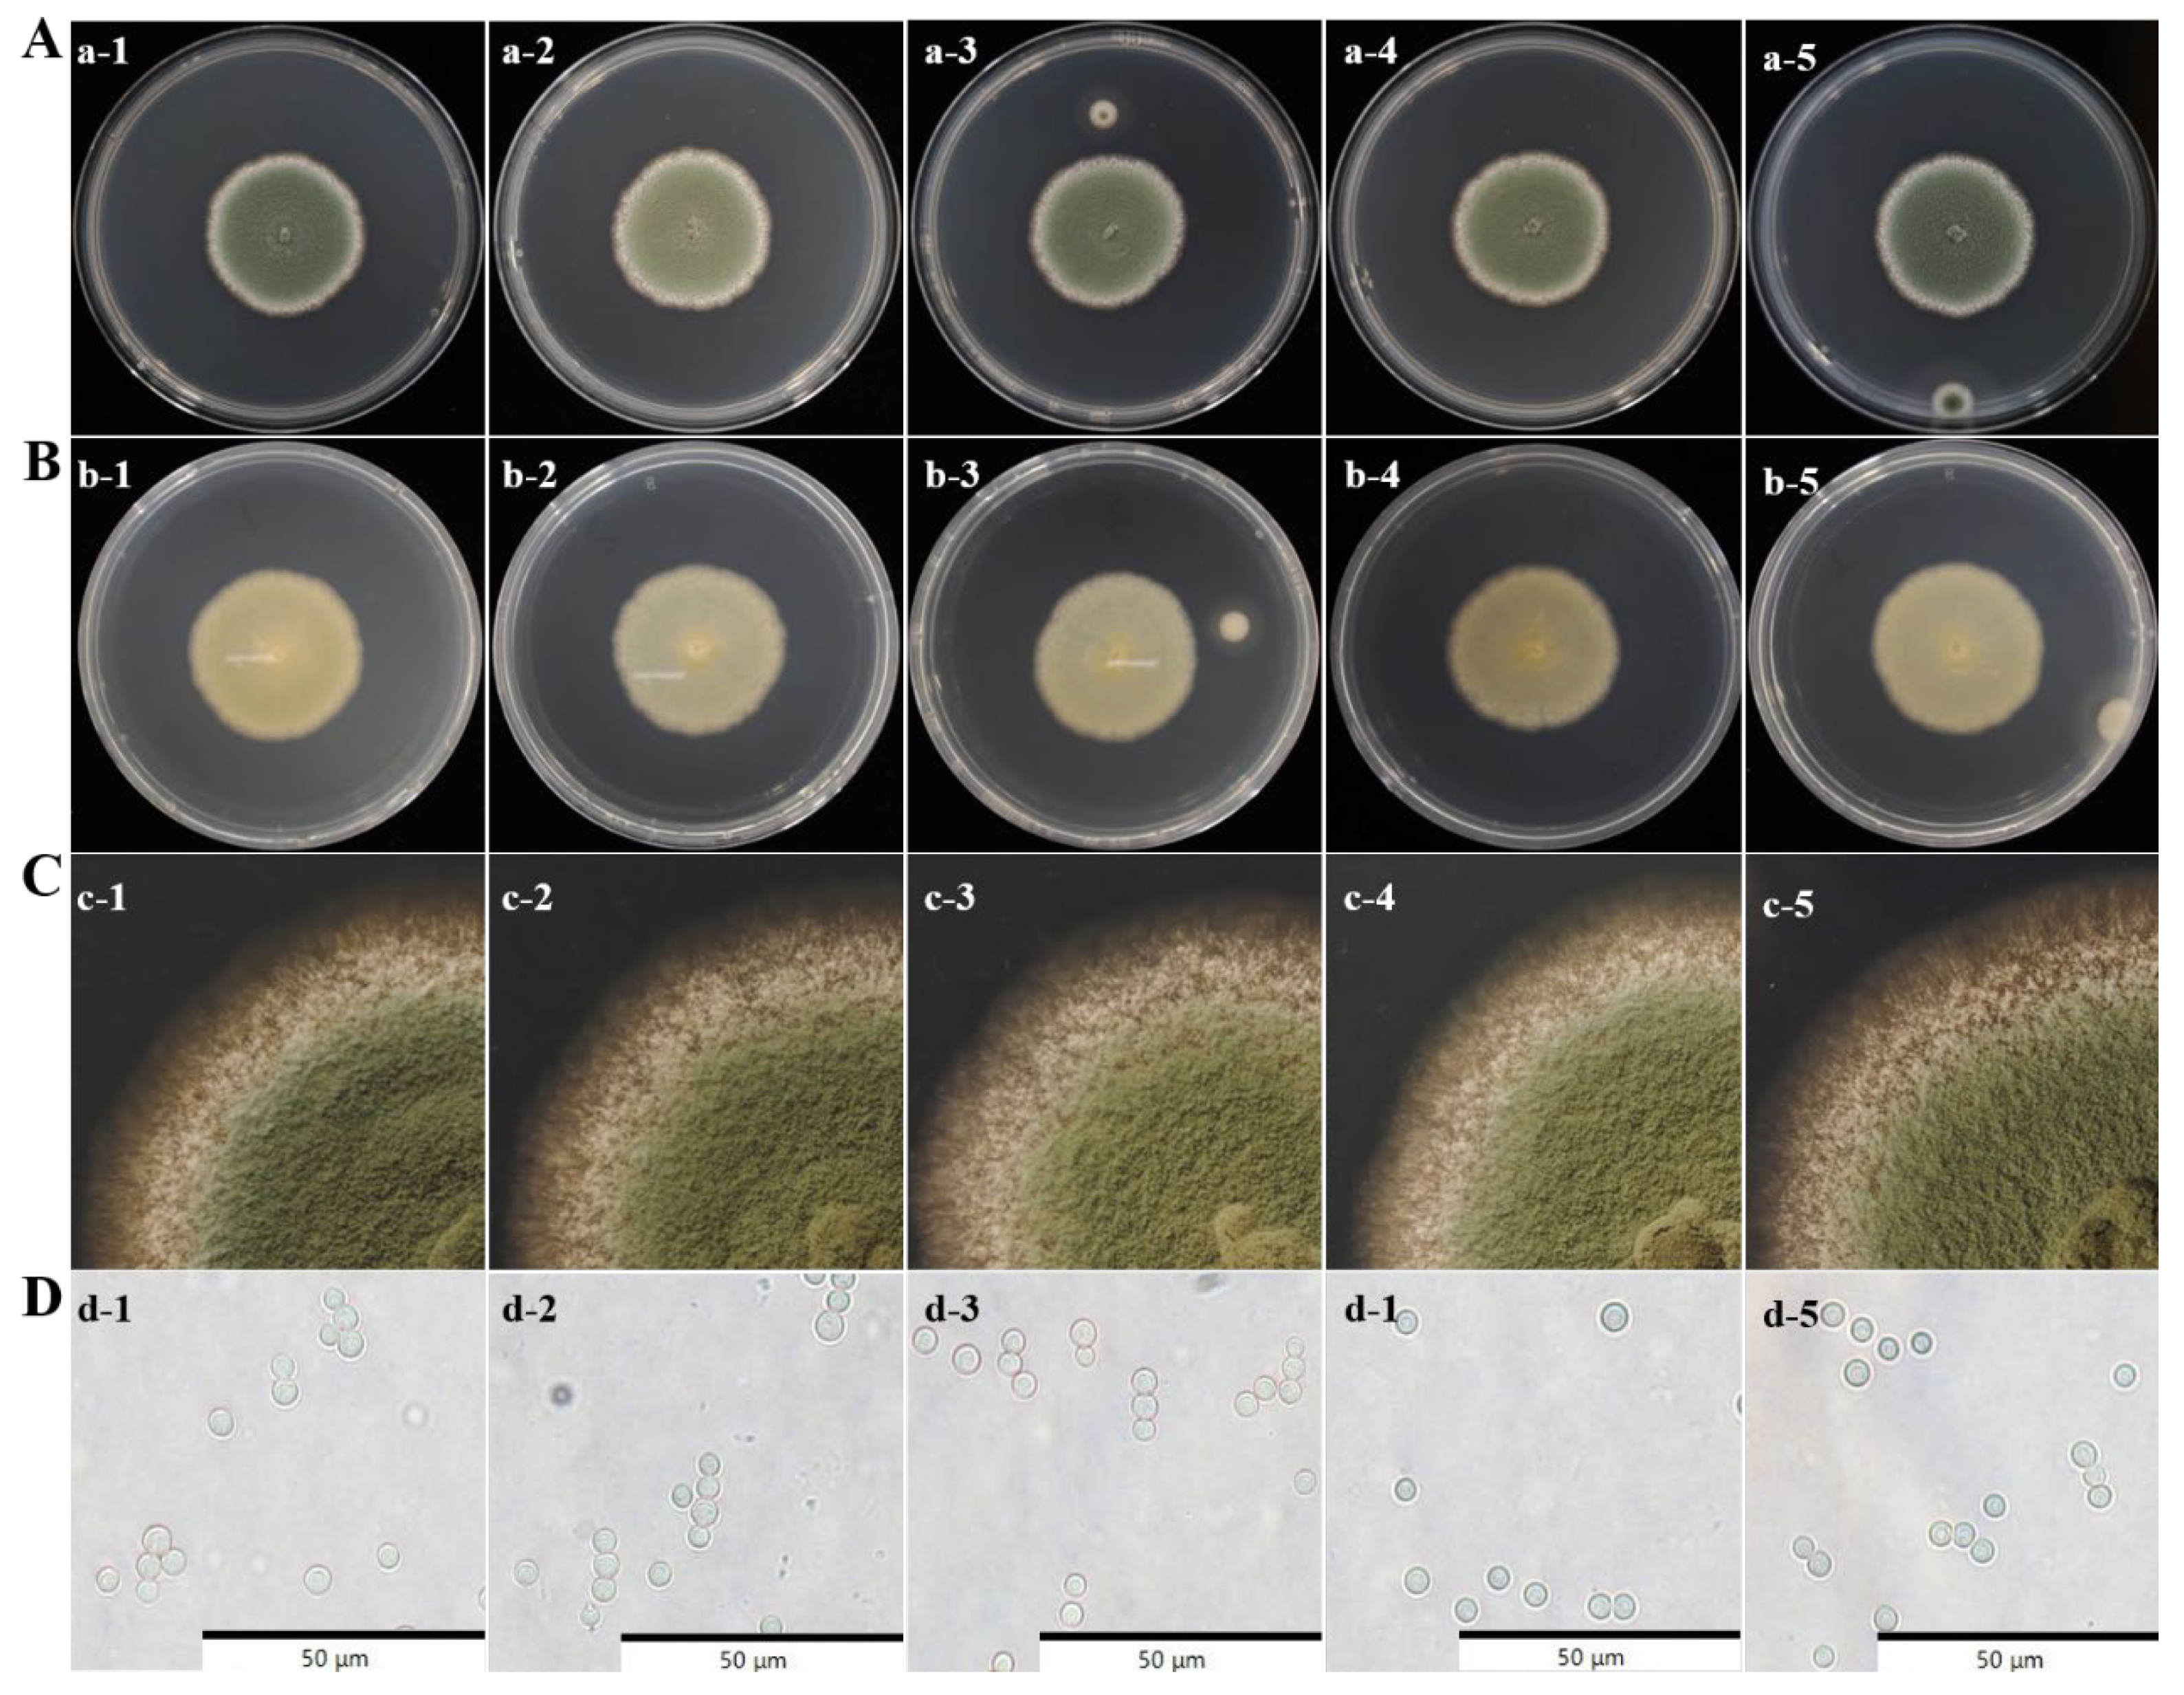

Isolation and Identification of Spoilage Fungi in Potato Fresh Wet Vermicelli and Inhibition Effect of Different Fungicides on Spoilage Fungi
Abstract
1. Introduction
2. Materials and Methods
2.1. Materials
2.2. Methodology
2.2.1. Spoilage Fungi Isolation and Purification
2.2.2. Morphology Analysis of Spoilage Fungi
2.2.3. PCR Analysis of Spoilage Fungi
2.2.4. Spoilage Potential Measurement
2.2.5. Growth Characteristics of Spoilage Fungi
2.2.6. Antifungal Effects of Different Inhibitors on Spoilage Fungi
2.3. Statistical Analysis
3. Results
3.1. Spoilage Symptoms of Fresh Wet Vermicelli During Storage
3.2. Morphology Observation of Spoilage Fungi
3.3. Molecular Analysis of Spoilage Fungi
3.4. Spoilage Ability of the Fungal Isolates
3.5. Growth Characteristics of P. crustosum
3.5.1. Colony Growth of P. crustosum at Different Temperatures and pH
3.5.2. Kinetics of Conidial Germination of P. crustosum
3.6. Inhibitory Effects of Different Antimicrobial Agents on P. crustosum
4. Discussion
5. Conclusions
Author Contributions
Funding
Institutional Review Board Statement
Informed Consent Statement
Data Availability Statement
Conflicts of Interest
References
- Feng, Y.Y.; Mu, T.H.; Zhang, M.; Ma, M.M. Effects of different polysaccharides and proteins on dough rheological properties, texture, structure and in vitro starch digestibility of wet sweet potato vermicelli. Int. J. Biol. Macromol. 2020, 148, 1–10. [Google Scholar] [CrossRef]
- Tan, H.Z.; Li, Z.G.; Tan, B. Starch noodles: History, classification, materials, processing, structure, nutrition, quality evaluating and improving. Food Res. Int. 2009, 42, 551–576. [Google Scholar] [CrossRef]
- Li, M.; Ma, M.; Zhu, K.-X.; Guo, X.-N.; Zhou, H.-M. Critical conditions accelerating the deterioration of fresh noodles: A study on temperature, pH, water content, and water activity. J. Food Process. Preserv. 2017, 41, e13173. [Google Scholar] [CrossRef]
- Gram, L.; Ravn, L.; Rasch, M.; Bruhn, J.B.; Christensen, A.B.; Givskov, M. Food spoilage-interactions between food spoilage bacteria. Int. J. Food Microbiol. 2002, 78, 79–97. [Google Scholar] [CrossRef] [PubMed]
- Jin, L.; Wu, Y.; Chen, Z.G. Inhibitory activity and mechanism of hydrogen peroxide on the dominant spoilage bacterium Bacillus aspergillus in fresh wet vermicelli. Food Ind. Sci. Technol. 2024, 45, 111–120. [Google Scholar]
- Bi, X.F.; Chen, Y.; Jiao, W.C.; Wang, X.Q. Bactericidal effect of ultra-high pressure on the spoilage mold of wet starch vermicelli and its induced quality changes. Mod. Food Sci. Technol. 2024, 40, 127–133. [Google Scholar]
- Avery, S.V.; Singleton, I.; Magan, N.; Goldman, G.H. The fungal threat to global food security. Fungal Biol. 2019, 123, 555–557. [Google Scholar] [CrossRef]
- Dong, H.Y.; Xu, Y.; Zhang, Q.Q.; Li, H.; Chen, L.X. Activity and safety evaluation of natural preservatives. Food Res. Int. 2024, 190, 114548. [Google Scholar] [CrossRef]
- Redondo-Blanco, S.; Fernández, J.; López-Ibáñez, S.; Miguélez, E.M.; Villar, C.J.; Lombó, F. Plant phytochemicals in food preservation: Antifungal bioactivity: A review. J. Food Prot. 2020, 83, 163–171. [Google Scholar] [CrossRef]
- Piper, J.D.; Piper, P.W. Benzoate and sorbate salts: A systematic review of the potential hazards of these invaluable preservatives and the expanding spectrum of clinical uses for sodium benzoate. Compr. Rev. Food Sci. Food Saf. 2017, 16, 868–880. [Google Scholar] [CrossRef]
- Teshome, E.; Forsido, S.F.; Rupasinghe, H.P.V.; Keyata, E.O. Potentials of natural preservatives to enhance food safety and shelf life: A review. Sci. World J. 2022, 2022, 9901018. [Google Scholar] [CrossRef] [PubMed]
- Mahmud, J.; Khan, R.A. Characterization of natural antimicrobials in food system. Adv. Microbiol. 2018, 08, 894–916. [Google Scholar] [CrossRef]
- Liao, W.Y.; Liu, X.L.; Zhao, Q.; Lu, Z.H.; Feng, A.Q.; Sun, X. Physicochemical, antibacterial and food preservation properties of active packaging films based on chitosan/ε-polylysine-grafted bacterial cellulose. Int. J. Biol. Macromol. 2023, 253 Pt 5, 127231. [Google Scholar] [CrossRef] [PubMed]
- He, L.; Zou, L.K.; Yang, Q.R.; Xia, J.H.; Zhou, K.; Zhu, Y.T.; Han, X.F.; Pu, B.; Hu, B.; Deng, W.W.; et al. Antimicrobial activities of nisin, tea polyphenols, and chitosan and their combinations in chilled mutton. J. Food Sci. 2016, 81, M1466–M1471. [Google Scholar] [CrossRef]
- Moro, C.B.; Lemos, J.G.; Gasperini, A.M.; Stefanello, A.; Garcia, M.V.; Copetti, M.V. Efficacy of weak acid preservatives on spoilage fungi of bakery products. Int. J. Food Microbiol. 2022, 374, 109723. [Google Scholar] [CrossRef]
- Buatong, J.; Preedanon, S.; Mittal, A.; Palamae, S.; Benjakul, S. Contaminated fungi in dried salted fishes: Isolation, identification, and their inhibition by chitooligosaccharide-gallic acid conjugate. J. Food Sci. 2023, 88, 4653–4663. [Google Scholar] [CrossRef]
- Ao, X.L.; Yan, J.L.; Chen, C.; Zhao, J.W.; Liu, S.L.; Zhao, K.; Chen, S.J.; He, L. Isolation and identification of the spoilage microorganisms in Sichuan homemade Paocai and their impact on quality and safety. Food Sci. Nutr. 2019, 7, 2939–2947. [Google Scholar] [CrossRef]
- Zhang, H.; Xi, J.H.; Liu, Z.G.; Chen, M.X.; Lu, Z.H.; Xue, H.L.; Bi, Y. Isolation and identification of pathogens causing blue mold of Lanzhou lily during postharvest storage and control of disease and mycotoxin accumulation by ozone treatment. J. Fungi 2023, 9, 1091. [Google Scholar] [CrossRef]
- Zhang, D.D.; Luo, K.J.; Wen, S.C.; Zhou, Q.; Li, B.C.; Liang, W.H.; Di, J.B. Isolation and identification of Aspergillus spp. from rotted walnuts and inhibition mechanism of Aspergillus flavus via cinnamon essential oil. Foods 2025, 14, 357. [Google Scholar] [CrossRef]
- Wang, R.X.; Zhang, H.; Zhang, Q.R.; Xi, J.H.; Jiang, K.H.; Li, J.Z.; Xue, H.L.; Bi, Y. Isolation, identification, and analyzing the biological characteristics of pathogens causing stem rot of Lanzhou onion during postharvest storage and studying the influence of pathogen Infection on the active components of Lanzhou onion. J. Fungi 2024, 10, 789. [Google Scholar] [CrossRef]
- Santos, J.L.P.D.; Bernardi, A.O.; Pozza Morassi, L.L.; Silva, B.S.; Copetti, M.V.; S Sant’Ana, A. Incidence, populations and diversity of fungi from raw materials, final products and air of processing environment of multigrain whole meal bread. Food Res. Int. 2016, 87, 103–108. [Google Scholar] [CrossRef] [PubMed]
- Cebrián, E.; Núñez, F.; Álvarez, M.; Roncero, E.; Rodríguez, M. Biocontrol of ochratoxigenic Penicillium nordicum in dry-cured fermented sausages by Debaryomyces hansenii and Staphylococcus xylosus. Int. J. Food Microbiol. 2022, 375, 109744. [Google Scholar] [CrossRef] [PubMed]
- Dagnas, S.; Onno, B.; Membré, J.M. Modeling growth of three bakery product spoilage molds as a function of water activity, temperature and pH. Int. J. Food Microbiol. 2014, 186, 95–104. [Google Scholar] [CrossRef] [PubMed]
- Abad, A.V.; Manzanares, P.; Marcos, J.F.; Martínez-Culebras, P.V. The Penicillium digitatum antifungal protein PdAfpB shows high activity against mycobiota involved in sliced bread spoilage. Food Microbiol. 2023, 109, 104142. [Google Scholar] [CrossRef]
- Gonda, M.; Rufo, C.; Cecchetto, G.; Vero, S. Evaluation of different hurdles on Penicillium crustosum growth in sponge cakes by means of a specific real time PCR. J. Food Sci. Technol. 2019, 56, 2195–2204. [Google Scholar] [CrossRef]
- Da Cruz Cabral, L.; Rodríguez, A.; Delgado, J.; Patriarca, A. Understanding the effect of postharvest tomato temperatures on two toxigenic Alternaria spp. strains: Growth, mycotoxins and cell-wall integrity-related gene expression. J. Sci. Food Agric. 2019, 99, 6689–6695. [Google Scholar] [CrossRef]
- Sardella, D.; Gatt, R.; Valdramidis, V.P. Modelling the growth of pear postharvest fungal isolates at different temperatures. Food Microbiol. 2018, 76, 450–456. [Google Scholar] [CrossRef]
- Amirpour, M.; Arman, A.; Yolmeh, A.; Azam, M.A.; Moradi-Khatoonabadi, Z. Sodium benzoate and potassium sorbate preservatives in food stuffs in Iran. Food Addit. Contam. Part B Surveill. 2015, 8, 142–148. [Google Scholar] [CrossRef]
- Yazdanfar, N.; Manafi, L.; Ebrahiminejad, B.; Mazaheri, Y.; Sadighara, P.; Basaran, B.; Mohamadi, S. Evaluation of sodium benzoate and potassium sorbate preservative concentrations in different sauce samples in Urmia, Iran. J. Food Prot. 2023, 86, 100118. [Google Scholar] [CrossRef]
- Guan, Z.; Feng, Q. Chitosan and chitooligosaccharide: The promising non-plant-derived prebiotics with multiple biological activities. Int. J. Mol. Sci. 2022, 23, 6761. [Google Scholar] [CrossRef]
- Burel, C.; Kala, A.; Purevdorj-Gage, L. Impact of pH on citric acid antimicrobial activity against Gram-negative bacteria. Lett. Appl. Microbiol. 2021, 72, 332–340. [Google Scholar] [CrossRef] [PubMed]
- Dai, Y.H.; Wei, J.R.; Chen, X.Q. Interactions between tea polyphenols and nutrients in food. Compr. Rev. Food Sci. Food Saf. 2023, 22, 3130–3150. [Google Scholar] [CrossRef] [PubMed]
- Li, Q.; Zhang, J.; Zhu, J.; Lin, H.; Sun, T.; Cheng, L. Effects of gallic acid combined with epsilon-polylysine hydrochloride incorporated in a pullulan-CMC edible coating on the storage quality of sea bass. RSC Adv. 2021, 11, 29675–29683. [Google Scholar] [CrossRef] [PubMed]
- Yu, H.L.; Su, L.H.; Jia, W.T.; Jia, M.J.; Pan, H.Y.; Zhang, X.H. Molecular mechanism underlying pathogenicity iInhibition by chitosan in Cochliobolus heterostrophus. J. Agric. Food Chem. 2024, 72, 3926–3936. [Google Scholar] [CrossRef]
- Yan, W.; Lang, W.; Lu, J.; Huang, C.; Li, X.; Dong, X.; Li, J. Isolation, identification and antibacterial screening of spoilage organism in guilin rice noodles. Food Industry Sci. Technol. 2024, 45, 140–146. [Google Scholar]
- Li, Y.X.; Zhang, J.; Lin, S.X.; Yang, L.; Sun, B.X.; Zhang, Y.H.; Xu, Y.F.; Yan, X.R. Antifungal effect and control of Alternaria fruit rot in blueberryy through ε-polylysine hydrochloride. Plant Physiol. Biochem. 2025, 222, 109694. [Google Scholar] [CrossRef]
- Demirok Soncu, E.; Özdemir, N.; Arslan, B.; Küçükkaya, S.; Soyer, A. Contribution of surface application of chitosan-thyme and chitosan-rosemary essential oils to the volatile composition, microbial profile, and physicochemical and sensory quality of dry-fermented sausages during storage. Meat Sci. 2020, 166, 108127. [Google Scholar] [CrossRef]
- Li, T.; Wang, Y.X.; Wang, B.G.; Zhou, J.H.; Xu, R.R.; Wang, Z.R. Isolation and identification of pathogenic bacteria causing rot in small watermelon fruits and study on the antibacterial effect of ε-polylysine. North. Hortic. 2025, 99–106. [Google Scholar] [CrossRef]

Disclaimer/Publisher’s Note: The statements, opinions and data contained in all publications are solely those of the individual author(s) and contributor(s) and not of MDPI and/or the editor(s). MDPI and/or the editor(s) disclaim responsibility for any injury to people or property resulting from any ideas, methods, instructions or products referred to in the content. |
© 2025 by the authors. Licensee MDPI, Basel, Switzerland. This article is an open access article distributed under the terms and conditions of the Creative Commons Attribution (CC BY) license (https://creativecommons.org/licenses/by/4.0/).
Share and Cite
Zhang, F.; Li, M.; Tian, J.; Ge, X.; Li, S.; Chen, J.; Li, Y.; Zhang, Y. Isolation and Identification of Spoilage Fungi in Potato Fresh Wet Vermicelli and Inhibition Effect of Different Fungicides on Spoilage Fungi. J. Fungi 2025, 11, 367. https://doi.org/10.3390/jof11050367
Zhang F, Li M, Tian J, Ge X, Li S, Chen J, Li Y, Zhang Y. Isolation and Identification of Spoilage Fungi in Potato Fresh Wet Vermicelli and Inhibition Effect of Different Fungicides on Spoilage Fungi. Journal of Fungi. 2025; 11(5):367. https://doi.org/10.3390/jof11050367
Chicago/Turabian StyleZhang, Feng, Mei Li, Jiachun Tian, Xia Ge, Shouqiang Li, Jianxin Chen, Yumei Li, and Yaqian Zhang. 2025. "Isolation and Identification of Spoilage Fungi in Potato Fresh Wet Vermicelli and Inhibition Effect of Different Fungicides on Spoilage Fungi" Journal of Fungi 11, no. 5: 367. https://doi.org/10.3390/jof11050367
APA StyleZhang, F., Li, M., Tian, J., Ge, X., Li, S., Chen, J., Li, Y., & Zhang, Y. (2025). Isolation and Identification of Spoilage Fungi in Potato Fresh Wet Vermicelli and Inhibition Effect of Different Fungicides on Spoilage Fungi. Journal of Fungi, 11(5), 367. https://doi.org/10.3390/jof11050367




